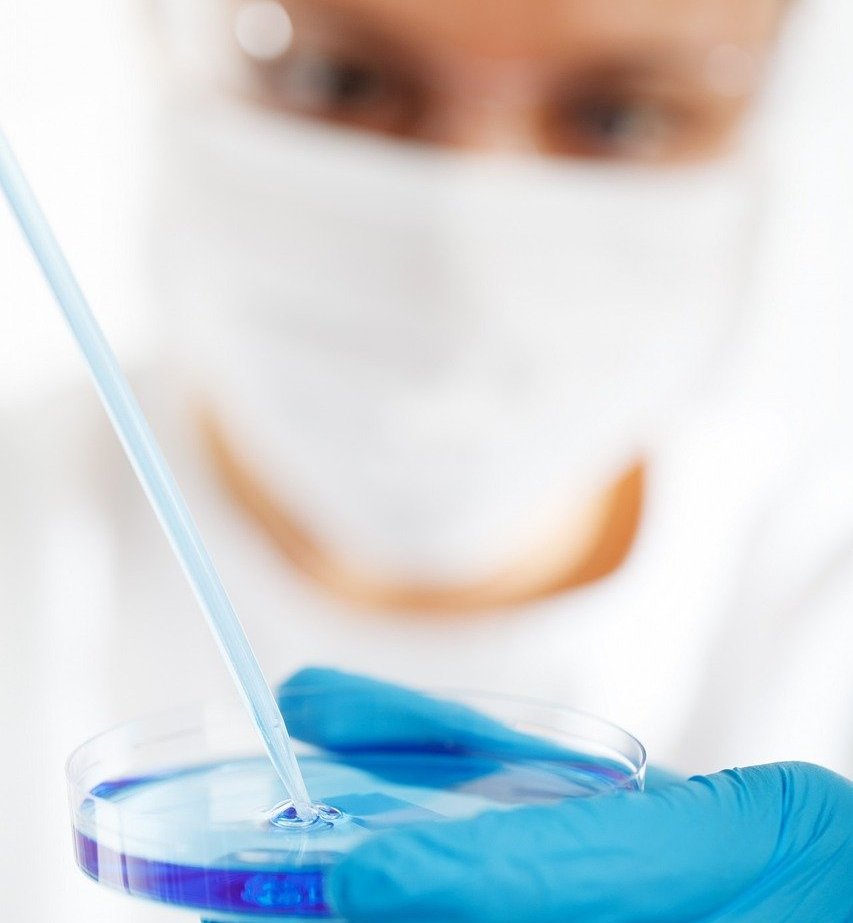

Estricto control de calidad.
La calidad lo es todo, por eso cuidamos cada parte del proceso para obtener resultados de la mayor calidad.

Cuidamos lo que hacemos
Cuidamos de cada una de las muestras que procesamos, conservandola en las mejores condiciones pre-analiticas

Expertos en cuidar tu salud
Contamos con un equipo de especialistas que están pendientes de que sus resultados cuenten con la más alta calidad.

Atentos a tus necesidades.
¿Ideas? ¿Proyectos o necesidades que son especiales? Estamos listos para ello. Cuéntanos de que se trata.
Contamos con el apoyo de médicos, enfermeras y personal de salud; ésto nos permite brindar servicios integrales en todos los niveles.
Tenemos la capacidad de enviar pruebas de alta especialidad al extranjero, sin costo adicional.
Unidad Sierra de Guadalupe:
Ruiseñor 4, Col. Sierra de Guadalupe, CP 54957, Tultitlán, Estado de México.
Tel. 55 8846 8842
Unidad Zona Escolar:
Av. Politécnico Nacional Mz. 64, ZOna Escolar, Gustavo A. Madero, 07230. Ciudad de México
Tel. 55 4215 0406